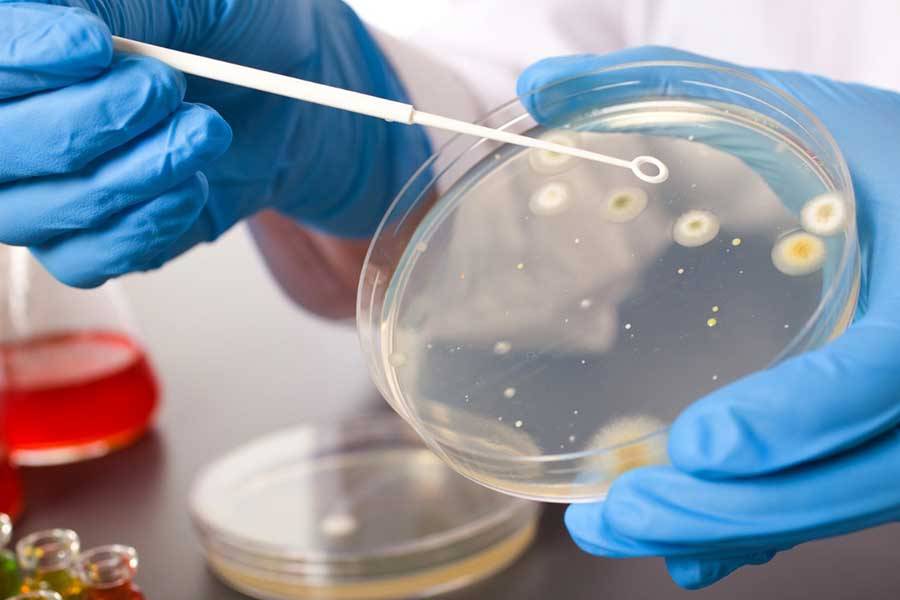

Когда использовать антибиотики?
Антибиотики могут быть бактериостатическими или бактерицидными. В первом случае они препятствуют размножению бактерий, во втором – они уничтожают живые клетки. При этом антибиотики эффективны только тогда, когда инфекция вызвана бактериями. Поэтому назначение антибиотика должно происходить только тогда, когда врач уверен, что инфекция бактериальная.
 Как принимать антибиотики
Как принимать антибиотики
К сожалению, тесты, подтверждающие этиологию инфекции, проводятся редко. При назначении антибиотика врачи обычно полагаются на конкретные симптомы бактериальной инфекции и место возникновения инфекции, зная, что определенные группы бактерий вызывают определенные симптомы.
Если у врача есть сомнения относительно происхождения заболевания, он обязан назначить анализ, подразумевающий посев биологической жидкости, например, мокроты, на специальную питательную среду. На таких средах бактерии быстро разрастаются, образуя колонии, хорошо различимые под микроскопом.
Затем можно воздействовать на выявленные бактерии разными антибиотиками, чтобы понять, какой из них будет уничтожать обнаруженный вид бактерий. Такой же анализ необходимо провести, если лечение уже назначенным антибиотиком остается неэффективным.
Сколько времени нужно на восстановление иммунитета
Срок реабилитации будет зависеть от различных факторов: возраст пациента, общее состояние здоровья, соблюдение предписаний врача, наличие сопутствующих заболеваний, степень тяжести, в которой он переносил ковид.
При легкой форме
Если даже болезнь протекала легко, в любом случае потребуется время на восстановление. Обычно на это уходит от 2 недель до 2 месяцев.
При средней степени тяжести
В этом случае уже чаще всего бывает необходима госпитализация. Однако пациент не находится долго в больнице. После выписки могут наблюдаться проблемы со здоровьем еще некоторое время. Как правило, на восстановление сил уходит около 3 недель.
При тяжелой форме заболевания
В этом случае пациенты в большинстве случаев находятся на ИВЛ. Даже когда их снимают с аппарата искусственной вентиляции легких, они еще долгое время пребывают под присмотром врачей. Опасность Covid-19 кроется в том, что не столько страшно само заболевание, сколько его последствия. Осложнения могут затронуть различные органы.
Ни в коем случае нельзя игнорировать препараты для иммунитета и поднятия сил после ковида, которые назначит врач и другие способы повышения защитной энергии. На восстановление придется потратить много времени, около полугода. В этот период нужно особенно тщательно следить за своим здоровьем, потому что очень высок риск заразиться какой-нибудь инфекцией, так как организм слабый.
Ошибка 3. Отсутствие защиты пищеварительной системы
Антибиотики смертельны не только для болезнетворных бактерий, но и для бактерий, которые колонизируют в пищеварительной системе и полезны для нашего здоровья. Результатом стерилизации организма является постантибиотическая диарея.
В рамках защиты полезных бактерий следует принимать защитные препараты – пробиотики как в виде лекарственных препаратов, так и натуральные – йогурт, кефир. Пробиотические препараты следует принимать примерно через час после введения антибиотика. Они также могут быть использованы после окончания антибиотикотерапии для ускорения восстановления бактериальной флоры в пищеварительной системе.
Посев на флору и антибиотики
Посев на флору и антибиотики
Пробиотики из аптеки или пробиотические бактерии в рационе
Какой пробиотик лучше? Врачи рекомендуют во время антибиотикотерапии принимать аптечные пробиотики, а после лечения сочетать прием аптечных препаратов с полезными продуктами.
Хорошие бактерии присутствуют в первую очередь йогурте, кефире, пахте. Чтобы продукт соответствовал требованиям пробиотического средства, он должен содержать в 1 грамме 100 млн единиц Lactobacillus (лактобацилл) или 10 млн единиц Bifidobacterium (бифидобактерий).
Употребление пищевых продуктов, содержащих пробиотики, полезно для здоровья, однако этого недостаточно в ситуации, когда нарушается физиологическая флора, в том числе из-за антибиотикотерапии. Кроме того, использование молочных продуктов во время антибиотикотерапии может препятствовать всасыванию антибиотика, поэтому вовремя лечения предпочтение отдается пробиотикам в форме препаратов.
Когда необходимо обратиться к врачу
Врач-терапевт расскажет, чем лечить отравление, вызванное приемом антибиотиков. В некоторых случаях может потребоваться комплексная диагностика состояния желудочно-кишечного тракта. Для диагностики врач проведет опрос, осмотр и пальпацию, после чего направит на обследование для выявления возможных сопутствующих причин и заболеваний.
Срочный визит к врачу нужен в следующих случаях:
- нестерпимая боль при опорожнении кишечника;
- примеси крови в стуле;
- высокая температура тела;
- тошнота, рвота;
- диарея трое суток подряд и более;
- обильный водянистый, пенистый, слизистый стул чаще 15 раз в сутки;
- нарушения сознания;
- симптомы обезвоживания или невозможность пополнить запас жидкости: сочетание диареи с неукротимой рвотой.
Не ограничивайтесь симптоматической помощью при диарее, полноценное лечение может назначить только врач. Откладывать визит к специалисту не стоит и в том случае, если перечисленные симптомы не связаны с настоящим или недавним курсом антибиотиков
Особенно важно получить срочную помощь людям старше 60 лет и лицам, страдающим хроническими заболеваниями желудочно-кишечного тракта, мочевыводящей системы, органов малого таза, системными и эндокринными заболеваниями.
Важно помнить, что у всех методов есть определенные ограничения, и только специалист может подсказать, как справиться с проблемой.
Статья имеет ознакомительный характер. Авторы не несут ответственности за качество оказания услуг третьими лицами и за возможные осложнения.
Список литературы
- Машарова А. А., Еремина Е. Ю. Пути профилактики кишечного дисбиоза у больных после антихеликобактерной терапии // Экспериментальная и клиническая гастроэнтерология. — 2009. — №8. — С. 108–111.
- Плоскирева А. А., Голден Л. Б. Антибиотикоассоциированный синдром в клинической практике // Гастроэнтерология. — 2018. — №2. — С. 58–61.
- Яковенко Э. П. Дисбактериоз кишечника // Лечебное дело. — 2004. — №3. — С. 3–8.
- Щербаков П. Л. Применение энтеросорбентов в лечении дисбиоза кишечника // Экспериментальная и клиническая гастроэнтерология. — 2009. — №3. — С. 88–92.
- Косюра С. Д., Ильченко Л. Ю., Пожарицкая Е. И., Мерзликина Н. Н. Антибиотик-ассоциированная диарея // Лечебное дело. — 2015. — №1. — С. 131–134.
Виды инфузионной терапии
Противовоспалительная инфузионная терапия с обезболивающим эффектом. Купирование болей различного характера (головных, болей при остеохондрозе и др.) в результате инфузионной терапии объясняется тем, что лекарства быстро поступают в кровь и насыщают ткани кислородом и глюкозой.
Для успешного лечения может применяться система инфузионной терапии. При сильных болевых приступах могут быть введены: анальгетики, противоотечные, противовоспалительные, успокоительные, миорелаксанты (для мышечного расслабления). Сочетания этих препаратов могут быть разными, оптимальное подбирает врач педиатр, терапевт, невролог или физиотерапевт.
Антибиотикотерапия инфузионная терапия.
Внутривенное введение антибиотиков обеспечивает быстрое воздействие этих препаратов, что чрезвычайно важно в некоторых ситуациях. Когда препараты вводятся непосредственно в кровоток, они очень скоро достигают места инфекции и мгновенно начинают действовать
В отличие от этого, препараты, принимаемые перорально, сначала всасываются в кишечнике и только потом начинают бороться с инфекцией. Внутривенные антибиотики гарантируют быстрый эффект.
Капельница для поддержания сердца и сосудов
Кровеносная система сердца довольно быстро изнашивается, что неизбежно приводит к патологиям сердца — самого главного органа человеческого организма.
- Капельницы с целью протекции сердца и сосудов
- Капельницы для восстановления сердечного ритма
- Капельницы при ишемической болезни сердца и с целью купирования стенокардии
- Лечение сердечно-сосудистой недостаточности
Капельницы для поддержки сердца и сосудов просто необходимы, потому что с их помощью можно максимально быстро восстановить структуру тканей и стенок, вернуть тонус сосудам и насытить органы полезными веществами.
Капельницы, поддерживающие работу сердца и сосудов с успехом назначают при следующих симптомах:
- болях в области сердца или за грудиной;
- нарушениях сердечного ритма (ощущения «замирания» или перебоев в работе сердца, сильное сердцебиение, неритмичный пульс);
- одышке;
- общей физической слабости, периодической слабости в руке или ноге;
- резких головокружениях или головных болях;
- временных нарушениях речи или зрения;
- повышенном артериальном давлении;
Капельница для улучшения мозгового кровообращения.
Проблемы с кровообращением в головном мозге — это не только головокружение и нарушения памяти, но и надвигающийся атеросклероз, спазмы сосудов и инсульты. Именно поэтому сосудам головного мозга лечение нужно своевременное. Капельницы же способны оказать должный эффект всего через несколько минут после начала введения, причем компоненты усваиваются практически полностью.
Для улучшения мозгового кровообращения применяют
- дезагреганты, препятствующие возникновению тромбов;
- ноотропы, улучшающие процессы обмена в голове;
- альфа-адреноблокаторы, расширяющие сосуды и ускоряющие клеточный метаболизм;
- спазмолитики;
- комбинированные средства.
Они стимулируют клеточный метаболизм и эффективно восстанавливают здоровье сосудов и тканей головного мозга
Благодаря такому действию эти лекарства способствуют нормальной циркуляции крови, улучшают внимание и его концентрацию, способствуют высокой умственной деятельности, эффективны после инсультов.. Капельницы очищающие организм, детоксицирующие капельницы.
Капельницы очищающие организм, детоксицирующие капельницы.
Это капельницы, содержащие такие препараты, при помощи которых из организма выводятся токсины (при аллергиях, ожирении, лекарственных отравлениях, пищевых и токсических отравлениях, при загрязненной экологии, курении, переедании и пр. негативных воздействиях на организм). Положительные эффекты следующие:
- снятие интоксикации, выведение токсинов и шлаков
- регенерация клеток печени
- улучшение качества жизни, активация умственной деятельности
- устранение синдрома хронической усталости, снятие стрессов и нервного напряжения
- избавление от бессонницы
- омоложение организма изнутри
- улучшение состояния кожи, внешней красоты и устранение признаков старения
Использование капельниц в лечении осложнений сахарного диабета.
Внутривенное введение препаратов может проводится и при плановом лечении больных диабетом. Для этого применяют препараты, которые действуют непосредственно на сосудистую стенку, улучшая микроциркуляцию и обменные процессы в тканях.
Показания к применению препаратов при сахарном диабете:
- Диабетическая полинейропатия.
- Микро- и макроангиопатия.
- Хронический гепатит.
- Гиперлипидемия и атеросклероз.
- Капельницы ставят от 10 до 20 дней, а в дальнейшем переходят на прием препарата в таблетках .
Осложнения
- Тромбоз. Характеризующется образованием в кровеносном русле кровяных сгустков – тромбов.
- Тромбофлебит. Заболевание, сопровождающееся воспалением внутренней оболочки вены и образованием тромба.
- Венозное кровотечение. Опасное осложнение, развивающееся на фоне повреждения варикозных узлов.
- Трофические язвы. Открытые воспаленные или гноящиеся раны на кожном покрове, возникающие в результате локального нарушения кровообращения, иннервации тканей и отторжении отмерших тканей.
- Перифлебит. Характеризуется воспалением тканей, окружающих пораженный сосуд.
- Тромбоэмболия легочной артерии. Сопровождается нарушением кровотока в легочной артерии в результате образования тромбов.
- Посттромбофлебитический синдром. Хроническая патология, которая сопровождается деформацией и разрушением сосудистых клапанов, а также образованием экзем.
Восстановление микрофлоры кишечника с помощью пробиотиков
Восстанавливать микрофлору кишечника после приема антибиотиков, скорее всего, понадобится на фоне следующих заболеваний и состояний:
бактериальные инфекции, требующие антибактериальной терапии, особенно длительной;
реабилитация после оперативных вмешательств, когда рекомендована профилактическая антибиотикотерапия;
инфекционная диарея;
перенесенная вирусная инфекция;
комплексное лечение аллергических и дерматологических заболеваний;
синдром раздраженного кишечника.
Избавьтесь от проблем с кишечником
Натуральный британский препарат не вызывает привыкания и действует сразу
Найти Фитомуцил с выгодой
Нормализовать микрофлору кишечника помогают пробиотики. Они содержат нормальную кишечную микрофлору, оказывающую терапевтическое действие и устраняющую явления дисбиоза. Принимать такие препараты следует курсом. Полезные бактерии заселяют кишечник и успешно справляются с условно-патогенной микрофлорой.
Чем еще можно восстановить микрофлору кишечника после антибиотиков? Особое значение в этом вопросе имеют пребиотики. Они выступают субстратом для питания и размножения полезной флоры. Бифидобактерии и лактобактерии восстанавливают нормальную работу пищеварительной системы.
Кроме того, пробиотики позволяют укрепить защитные силы организма, улучшить пищеварение, способствуют выработке витаминов В, К и обладают другими терапевтическими эффектами.
Режим дозирования, курс лечения и способ введения
Препарат применяют детям с периода новорожденности и взрослым.
При острой кишечной инфекции, пищевой токсикоинфекции, диарее:
- детям до 6 месяцев по 1 пакету/капсуле 2 раза в день; детям старше 6 месяцев по 1 пакету/капсуле 3-4 раза в день (возможно с коротким интервалом в 2-3 часа), курсом 2-3 дня; при сохранении клинических симптомов курс лечения удлиняется до4-5 дней;
- детям старше 7 лет и взрослым по 2-3 пакета/капсулы 2 раза в день, курс лечения 3-5 дней,
- взрослым для прекращения диареи в ранние сроки заболевания по 3 пакета/капсулы 2 раза в день с интервалом 30 минут — 1 час, дозировку можно увеличить до 6 пакетов/капсул одномоментно на прием 1 раз в день, курс лечения 1-3 дня.
При хронической патологии:
| Порошок | Капсулы |
| желудочно-кишечного тракта и функциональныхкишечных нарушениях — детям и взрослым однократно 3 пакета во время вечернего приема пищи, взрослым — возможно по 2 пакета 2 раза в день. Курс лечения 5-15 дней. При тяжелом течении заболевания количество принимаемого препарата можно увеличить детям с 1 года и взрослым до 6 пакетов в сутки, а курс увеличить до 30 дней. | желудочно-кишечного тракта, синдроме раздраженногокишечника — детям по 3 капсулы однократно во время вечернего приема пищи,взрослым по 3 капсулы однократно или по 2 капсулы 2 раза в день. Курс лечения 5-15дней. При тяжелом течении заболевания количество принимаемого препарата можноувеличить взрослым и детям до 6 капсул в день, а курс лечения увеличить до 30 дней. |
При дисбактериозах различной этиологии, хронических кишечных инфекциях, у больных с иммунодефицитными состояниями, с кожными заболеванииями, а также для улучшения течения периода адаптации у новорожденных детей:
недоношенным новорожденным по 1 пакета/капсуле 1-2 раза в день;
доношенным новорожденным и детям до 3 лет по 1 пакета/капсуле 2 раза в день;
детям с 3 до 7 лет – по 1 пакета/капсуле 3 раза в день;
детям старше 7 лет и взрослым по 2-3 пакета/капсулы 2 раза в день.
Курс лечения 7-10 дней.
В комплексном лечении острых респираторных вирусных инфекций и гриппа — пациентам всех возрастных групп с 1-2 дня заболевания по 1 пакете/капсуле 3 раза в день.Курс лечения 2 дня.Хирургическим больным, беременным женщинам при подготовке к кесареву сечениюс целью снижения послеоперационных осложнений:
- до операции по 1 пакете/капсуле 3 раза в день в течение 2-3 дней; лицам, страдающим дисбактериозом кишечника, получавшим антибиотики и химиопрепараты, предоперационный курс удлиняется до 7 дней,
- со 2-7 дня после операции по 1 пакете/капсуле 3 раза в день в течение 2-3 дней, по показаниям – 7-10 дней.Пробифор принимают внутрь во время приема пищи, при необходимости независимо от приема пищи, запивая водой. Детям и пациентам, которые не могут проглотить целую капсулу ее вскрывают. Содержимое пакета/капсулы смешивают с жидкой пищей, желательно кисломолочным продуктом, новорожденным и детям грудного возраста — с материнским молоком или смесью для искусственного вскармливания. Можно смещать содержимое пакета/капсулы с 30-50 мл кипяченой воды комнатной температуры, при этом образуется мутная взвесь с частичками сорбента черного цвета. Полученную водную взвесь следует выпить, не добиваясь полного растворения.
Пробиотик с антибиотиком – как использовать?
- Для правильного восстановления физиологической флоры пробиотик следует использовать не только во время антибиотикотерапии, но и после нее. Пробиотик после приема антибиотика следует принимать не менее недели, оптимально в течение двух недель после завершения основного лечения.
- Между введением антибиотика и пробиотика должен быть интервал не менее двух часов. Одновременное использование обоих препаратов приводит к тому, что антибиотик также уничтожает бактерии, содержащиеся в пробиотическом препарате.
- Некоторые пробиотики следует хранить в холодильнике.
- Можно использовать пробиотики, требующие самостоятельного приготовления питьевой суспензии.
Реакция микрофлоры кишечника на прием антибиотиков
Реакция на антибактериальную терапию со стороны желудочно-кишечного тракта может быть разной. Так, развитие антибиотик-ассоциированной диареи объясняется нарушением функционирования микрофлоры кишечника: уменьшается количество полезных бактерий, что приводит к увеличению численности условно-патогенной флоры, в частности Clostridium difficile.
В результате развивается опасное заболевание — псевдомембранозный энтероколит. В остальных случаях к диарее может привести изменение микрофлоры кишечника после антибиотиков в виде активного размножения золотистого стафилококка, клебсиеллы, грибков Candida, сальмонелл.
Существуют и другие механизмы развития поноса: из-за снижения числа полезных бактерий нарушаются обменные процессы, в том числе переваривание и всасывание углеводов, клетчатки. Секреция воды в просвет кишки приводит к разжижению стула.
Но уменьшение количества бифидобактерий и лактобактерий не всегда приводит к диарее. Иногда дисбактериоз сопровождается запорами или чередованием задержки стула и диареи. К симптомам дисбактериоза относят также вздутие, урчание в животе, тошноту, потерю аппетита и другие проявления.
Чем можно заменить Про-Колин
Про-Колин — дорогостоящая добавка к корму, поэтому не каждый владелец кошки может её приобрести. К счастью, фармацевтический рынок ветеринарных препаратов готов предложить потребителю и другие средства, нормализующие работу органов пищеварения.
Аналоги средства:
- Ветелакт;
- Флорентин;
- Субтилис;
- Бифитрилак МК;
- Энтерол.
Первые четыре препарата в списке относятся к числу кормовых добавок, Энтерол — к лекарственным средствам.
Данные препараты не рекомендуется применять без консультации с ветеринарным врачом.
Таблица: аналоги пищевой добавки
| Торговое название | Форма реализации | Состав | Показания к применению препарата | Противопоказания | Негативные реакции | Ориентировочная стоимость |
| Ветелакт | Сироп для приёма внутрь |
|
| Не имеет | О случаях негативных реакций после применения данной кормовой добавки неизвестно | 20 мл — 125 р. |
| Флорентин |
|
|
ослабление организма после дегельминтизации и инфекционных заболеваний. | Гиперчувствительность к компонентам кормовой добавки | Не наблюдаются |
|
| Субтилис |
|
молочная кислота. |
| Отсутствуют | 10 туб суспензии дозировкой по 1 мл — 460 р. | |
| Бифитрилак МК | Порошок |
|
| Индивидуальная непереносимость состава пробиотика | Не наблюдаются | 400 грамм порошка — 300 р. |
| Энтерол (противодиарейное средство, используется для лечения людей и животных) | Капсулы |
|
| Гиперчувствительность к компонентам препарата |
| 30 капсул — 500 р. |
Фотогалерея: средства на замену препарату Про-Колин
При следовании инструкции побочных реакций после применения Флорентина не наблюдаетсяСубтилис отпускается без рецепта ветеринарного врачаЭнтерол применяется для лечения дисфункций пищеварения как у людей, так и у кошекБифитрилак — это смесь для нормализации состояния желудочно-кишечного тракта у животныхВетелакт стимулирует рост полезных бифидо- и лактобактерий, способствует подавлению роста патогенной микрофлоры
Проведение инфузионной терапии
Внутривенные вливания должен проводить только квалифицированный специалист, который знаком с особенностями введения различных веществ, их сочетанием и возможной реакцией организма пациента
Особое внимание уделяется скорости введения инфузионного раствора с растворенными средствами. Доверяйте свое здоровье только действующим профессионалам
Это позволит избежать неблагоприятных последствий для здоровья: появления гематомы, аллергической реакции, боли и покраснения.
Сначала место введения препарата (как правило, это локтевой сгиб) обрабатывается антисептиком. Вена подготавливается традиционным способом с помощью жгута и фиксируется натягиванием кожи. Игла вводится тогда, когда кисть сжата в кулак; жгут снимается при появлении крови в канюле иглы. Далее к канюле присоединяется инфузионная система и открывается зажим, открывая ход току жидкости. Скорость капель регулируется в зависимости от рекомендаций врача.
Во время процедуры за процессом следит медицинская сестра
В конце процедуры зажим перекрывается, игла осторожно вытаскивается из вены при использовании ватного диска, смоченного антисептиком. Как правило, место внутривенного вливания забинтовывают с целью остановки кровотечения.
Биологические свойства
Антидиарейное действие препарата обусловлено высокой концентрацией сорбированных на частицах активированного угля бифидобактерий (Bifidobacterium bifidum № 1), являющихся антагонистами широкого спектра патогенных (шигеллы, сальмонеллы, золотистый стафилококк и др.) и условнопатогенных микроорганизмов (протей, клебсиелла и др.).Противоинфекционное действие препарата усилено за счет сорбции бифидобактерий на частицах угля, что приводит к ускоренной нормализации микробиоценоза желудочно-кишечного тракта, активизации восстановительных процессов в слизистых оболочках и повышению противоинфекционной резистентности организма.Антитоксическое действие препарата обеспечивается быстрым заселением кишечника микроколониями бифидобактерий, восстановлением нормальной микрофлоры, которая препятствует проникновению токсинов во внутреннюю среду организма и, являясь естественным биосорбентом, аккумулирует в значительном количестве попадающие извне или образующиеся в организметоксические вещества.Бифидобактерии в высокой концентрации активизируют пристеночное пищеварение кишечника, синтез витаминов и аминокислот, усиливают защитную функцию кишечника и иммунную защиту организма.
Показания для применения
- пищевые токсикоинфекции;
- острые кишечные инфекции бактериальной и вирусной природы (сальмонеллезы, шигеллезы, энтероколиты, вызванные патогенными представителями рода энтеробактерий или стафилококками, ротавирусная инфекция) или неустановленнойэтиологии;
- дисбактериозы различной этиологии, в том числе развившиеся на фоне и после приема антибиотиков, цитостатической, лучевой терапии; осложняющие течение вирусных гепатитов, цирроза печени, дивертикулеза кишечника различной локализации;
- новорожденным (в т.ч. недоношенным) детям с отягощенным преморбидным фоном, начиная с периода пребывания в родильном доме, для улучшения течения периодаадаптации, а также при выраженных дисбактериозах;
- беременным женщинам при подготовке к родам, кесареву сечению и в послеоперационном периоде.Препарат применяется в составе комплексной терапии
- хронических инфекционных и неспецифических воспалительных заболеваний пищеварительного тракта (гастродуоденит, панкреатит, проктосигмоидит, колит, в том числе язвенный колит);
- больных с вторичными иммунодефицитными состояниями, при тяжелых инфекционно-воспалительных и гнойно-септических заболеваниях (сепсис, перитонит и др.); с кожными заболеваниями (атопический дерматит, стрептодермия, экзема);
- синдрома раздраженного кишечника;
- острых респираторных вирусных инфекций и гриппа;
- хирургических больных (в т.ч. травматологического профиля) для предоперационной подготовки и профилактики послеоперационных осложнений; при постгастрорезекционных расстройствах и состояниях после холецистэктомий;
- онкологических больных при проведении химиотерапии, лучевой терапии, до и после хирургических вмешательств.
| Порошок |
| — синдрома раздраженного кишечника, других функциональных кишечных нарушений;— синдрома нарушенного кишечного всасывания различной этиологии. |

































